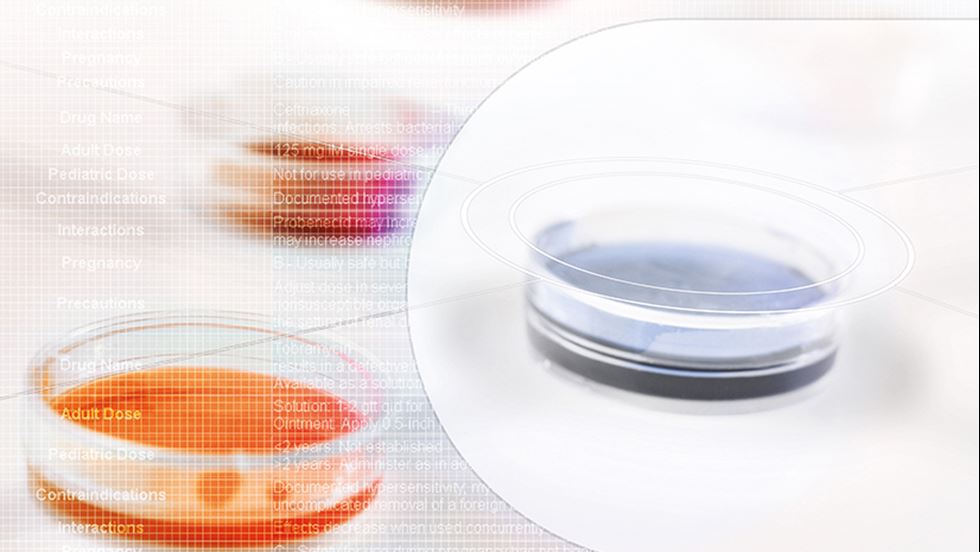

Forskningsdelegationens Prioriteringskommitté
Ordförande Anna Sarkadi, Uppsala universitet
Vice ordförande
Ledamöter
Anders Jeppsson, Göteborgs universitet
Andreas Stomby, Linköpings universitet
Annette Bruchfeld, Linköpings Universitet
Bo Norrving, Lunds universitet
Carl Turesson, Skånes universitetssjukhus
David Lindquist, Umeå univeritet
Eva Andersson, Gymnastik- och idrottshögskolan
Eva Marie Erfurth, Lunds universitet
Gabriella Palmer, Karolinska Institutet
Hannes Hagström, Karolinska Institutet
Hans Thulesius, Lunds univeritet
Håkan Olausson, Linköpings universitet
Joakim Nordanstig, Sahlgrenska Universitetssjukhuset
Johan Ursing, Karolinska Institutet
Johan Wikström, Uppsala universitet
Katarina Hedin, Linköpings universitet
Kristina Bengtsson Boström, Lunds universitet
Lars-Magnus Andersson, Sahlgrenska Universitetssjukhuset
Lil Träskman Bendz, Lunds universitet
Martin Rutegård, Umeå universitet
Olof Grip, Lunds universitet
Per Stål, Karolinska Institutet
Rose-Marie Amini, Uppsala universitet
Stefan Hansson, Lunds universitet
Stefan Söderberg, Umeå universitet
Stig Attvall, Göteborgs universitet
Stina Syvänen, Uppsala universitet
Ansökningar
Svenska Läkaresällskapets webbplats för ansökningar om bidrag ur våra fonder.
Frågor
För frågor om ansökningsförfarandet:
Karina Umander
karina.umander@sls.se
070-695 6095
För frågor om medlemskap:
medlem@sls.se
08-440 88 89
